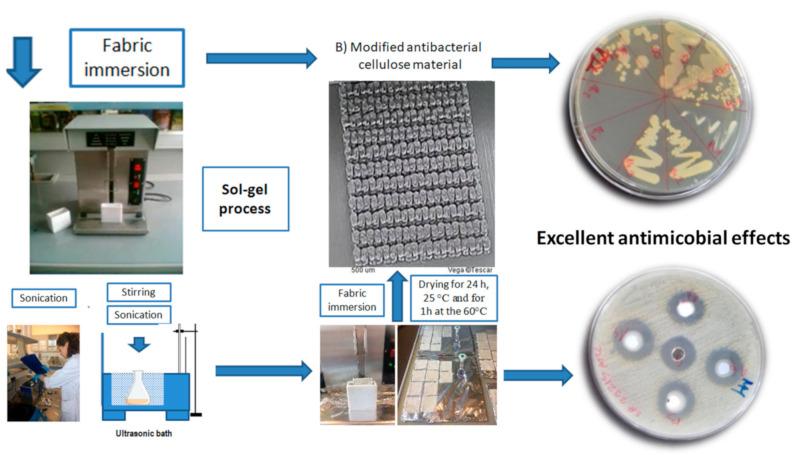
https://cdn.ncbi.nlm.nih.gov/pmc/blobs/1e5e/7926737/5f8ebb447d15/polymers-13-00659-g001.jpg

在可生物降解聚合物上开发对甲氧西林敏感金黄色葡萄球菌(MSSA)和耐甲氧西林金黄色葡萄球菌(MRSA)具有活性的抗菌保护涂层。
Development of Antibacterial Protective Coatings Active against MSSA and MRSA on Biodegradable Polymers.
作者信息
Rezić Iva, Majdak Mislav, Ljoljić Bilić Vanja, Pokrovac Ivan, Martinaga Lela, Somogyi Škoc Maja, Kosalec Ivan
机构信息
Department of Applied Chemistry, Faculty of Textile Technology, University of Zagreb, 10000 Zagreb, Croatia.
Faculty of Pharmacy and Biochemistry, Institute for Microbiology University of Zagreb, 10000 Zagreb, Croatia.
出版信息
Polymers (Basel). 2021 Feb 23;13(4):659. doi: 10.3390/polym13040659.
In this work the in vitro antimicrobial activity of colloidal solutions of nine different commercially available nanoparticles were investigated against strains, both methicillin-sensitive (MSSA) and methicillin-resistant (MRSA). Research covered antimicrobial investigation of different metal and metal-oxide nanoparticles, including Ag 10 nm, Ag 40 nm, AlO 100 nm, Au 20 nm, Pt 4 nm, TiO 100 nm, YO 100 nm, ZnO 100 nm and ZrO 100 nm nanoparticles. Such materials were foreseen to be applied as coatings on 3D-printed biodegradable polymers: i.e., catheters, disposable materials, hospital bedding items, disposable antimicrobial linings and bandages for chronic wounds. Therefore, the antimicrobial activity of the nanoparticles was determined by agar well diffusion assays and serial microdilution broth assays. In addition, the chromatographic characterization of elements present in trace amounts was performed as a method for tracing the nanoparticles. Moreover, the potential of preparing the rough surface of biodegradable polymers for coating with antimicrobial nanoparticles was tested by 3D-printing fused deposition methodology. The in vitro results have shown that particular nanoparticles provided powerful antimicrobial effects against MSSA and MRSA strains, and can be easily applied on different biopolymers.
在这项工作中,研究了九种不同市售纳米颗粒胶体溶液对甲氧西林敏感菌株(MSSA)和甲氧西林耐药菌株(MRSA)的体外抗菌活性。研究涵盖了不同金属和金属氧化物纳米颗粒的抗菌研究,包括10纳米银、40纳米银、100纳米氧化铝、20纳米金、4纳米铂、100纳米二氧化钛、100纳米氧化钇、100纳米氧化锌和100纳米氧化锆纳米颗粒。预计此类材料将用作3D打印可生物降解聚合物上的涂层,如导管、一次性材料、医院床上用品、一次性抗菌衬里以及慢性伤口绷带。因此,通过琼脂孔扩散试验和系列微量稀释肉汤试验测定纳米颗粒的抗菌活性。此外,对痕量元素进行色谱表征,作为追踪纳米颗粒的一种方法。此外,通过3D打印熔融沉积方法测试了制备用于抗菌纳米颗粒涂层的可生物降解聚合物粗糙表面的潜力。体外结果表明,特定的纳米颗粒对MSSA和MRSA菌株具有强大的抗菌作用,并且可以轻松应用于不同的生物聚合物上。